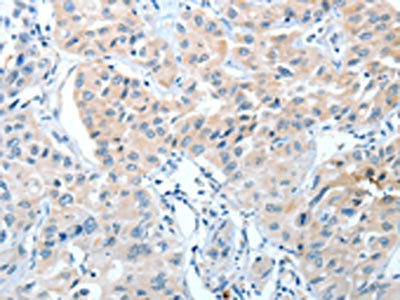

-
中文名稱:IL22RA1兔多克隆抗體
-
貨號:CSB-PA279247
-
規格:¥1100
-
圖片:
-
The image on the left is immunohistochemistry of paraffin-embedded Human liver cancer tissue using CSB-PA279247(IL22RA1 Antibody) at dilution 1/15, on the right is treated with fusion protein. (Original magnification: ×200)
-
The image on the left is immunohistochemistry of paraffin-embedded Human lung cancer tissue using CSB-PA279247(IL22RA1 Antibody) at dilution 1/15, on the right is treated with fusion protein. (Original magnification: ×200)
-
-
其他:
產品詳情
-
Uniprot No.:
-
基因名:
-
別名:CRF2 9 antibody; CRF2-9 antibody; Cytokine receptor class-II member 9 antibody; cytokine receptor classII member 9 antibody; Cytokine receptor family 2 member 9 antibody; I22R1_HUMAN antibody; IL-22 receptor subunit alpha-1 antibody; IL-22R-alpha-1 antibody; IL-22RA1 antibody; IL22 Receptor Alpha antibody; IL22R antibody; IL22R1 antibody; Il22ra1 antibody; ILTIF R1 chain antibody; Interleukin 22 Receptor alpha 1 antibody; Interleukin 22 Receptor antibody; Interleukin-22 receptor subunit alpha-1 antibody; ZcytoR11 antibody
-
宿主:Rabbit
-
反應種屬:Human
-
免疫原:Fusion protein of Human IL22RA1
-
免疫原種屬:Homo sapiens (Human)
-
標記方式:Non-conjugated
-
抗體亞型:IgG
-
純化方式:Antigen affinity purification
-
濃度:It differs from different batches. Please contact us to confirm it.
-
保存緩沖液:-20°C, pH7.4 PBS, 0.05% NaN3, 40% Glycerol
-
產品提供形式:Liquid
-
應用范圍:ELISA,IHC
-
推薦稀釋比:
Application Recommended Dilution ELISA 1:1000-1:2000 IHC 1:15-1:50 -
Protocols:
-
儲存條件:Upon receipt, store at -20°C or -80°C. Avoid repeated freeze.
-
貨期:Basically, we can dispatch the products out in 1-3 working days after receiving your orders. Delivery time maybe differs from different purchasing way or location, please kindly consult your local distributors for specific delivery time.
-
用途:For Research Use Only. Not for use in diagnostic or therapeutic procedures.
相關產品
靶點詳情
-
功能:Component of the receptor for IL20, IL22 and IL24. Component of IL22 receptor formed by IL22RA1 and IL10RB enabling IL22 signaling via JAK/STAT pathways. IL22 also induces activation of MAPK1/MAPK3 and Akt kinases pathways. Component of one of the receptor for IL20 and IL24 formed by IL22RA1 and IL20RB also signaling through STATs activation. Mediates IL24 antiangiogenic activity as well as IL24 inhibitory effect on endothelial cell tube formation and differentiation.
-
基因功能參考文獻:
- increased expression of IL-22Ralpha therefore promotes keratinocyte proliferation and pro-inflammatory cytokine production during UVB-induced skin inflammation, suggesting that UVB facilitates skin inflammation by increasing the responsiveness of keratinocytes to IL-22 PMID: 28558005
- IL-22 and its receptor have a crucial role in the development and pathogenesis of uveitis by facilitating inflammatory cell infiltration. PMID: 27166675
- high expression profile of IL-22R1 in nonsmall cell lung cancer is an independent indicator of poor overall survival PMID: 26846835
- phosphorylation of STAT3 and AKT was highly induced by treatment with IL-22 via IL-22R1. IL-22R1 was also consistently overexpressed in recurrent NSCLC tissues PMID: 26983629
- These data suggest that imbalance of IL-22/IL-22R1 signaling regulates the pathogenesis of chronic rhinosinusitis with nasal polyps, including local eosinophilia, via alteration of MUC1 expression. PMID: 27502468
- FBXW12 functions as an E3 ligase constituent to ubiquitinate and degrade IL-22R and that therapeutic FBXW12 inhibition may enhance IL-22 signaling and bolster mucosal host defense and infection containment. PMID: 26171402
- IL-22R1 is over-expressed in primary Sjogren's syndrome and Sjogren-associated non-Hodgkin lymphomas and is regulated by IL-18. PMID: 25880879
- IL-22 has restricted tissue specificity as its unique receptor IL-22R1 is exclusively expressed on epithelial and tissue cells, but not immune cells. PMID: 24856143
- serum IL-22 levels are significantly higher in patients with pituitary macroadenomas than in healthy controls and IL-22R is variably expressed in both prolactinoma and non-functioing pituitary adenoma cells. PMID: 23512698
- High expression of interleukin-22 receptor is associated with pancreatic ductal adenocarcinoma. PMID: 24132627
- the CC genotype of rs3795299 polymorphism in the IL-22R1 gene is associated with the reduced risk of IgAN, and this genetic association was supported by the higher renal expression of IL-22R1 in healthy controls compared with patients with IgAN. PMID: 23659670
- Letter: calcipotriol inhibits the IL-22-induced epidermal hyperplasia by decreasing keratinocyte proliferation and down-modulating IL-22R expression. PMID: 23688404
- Data show that IL-17RA, IL-17RC, IL-22R1, ERK1/2 MAPK and NF-kappaB pathways are involved in Th17 cytokine-induced proliferation. PMID: 22898922
- IL-22R1 mRNA and protein expressions in HASMCs were significantly increased after stimulation by serum from asthmatic patients, but decreased after co-stimulation with dexamethasone. PMID: 21690049
- This study documents a previously unknown role of IL-22R1 in inflammation and identifies the involvement of IL-22R1/IL-22 in anaplastic lymphoma kinase-positive anaplastic large cell lymphoma PMID: 20971950
- Tyr251 and Tyr301 of IL-22R1 are required for Shp2 binding and IL-22-induced Erk1/2 activation. PMID: 20671117
- study demonstrated IL-22R1 mRNA and protein expression on nasal epithelial cells; failure of medical and surgical therapy in chronic rhinosinusitis with nasal polyps is associated with significantly decreased expression of IL-22R1 PMID: 17906500
- The islets of Langerhans are the local site for IL-22R1 expression in the human pancreas. PMID: 18376313
- Molecular basis for the distinct affinities and specificities of IL-22 and IL-10 receptor chains that regulate cellular targeting and signal transduction to elicit effective immune responses. PMID: 18599299
- A 1.9A crystal structure of the IL-22/IL-22R1 complex is reported. PMID: 18675809
- identifies those amino acid side chains of IL-22 that are individually important for optimal binding to IL-22R PMID: 18675824
- Comparison of IL-22/IL-22BP and IL-22/IL-22R1 crystal structures shows that both receptors display an overlapping IL-22 binding surface, which is consistent with the inhibitory role played by IL-22 binding protein. PMID: 19285080
- Data show that deletion of the C-terminal part of IL-22R dramatically decreased its ability to activate STAT3. PMID: 19632985
- Increased IL-22R expression in epidermal keratinocytes contributes to the pathogenesis of psoriasis through enhancing the coordinated effects of IL-22 and IL-17, inducing the production of the IL-20 subfamily, chemokines, and growth factors. PMID: 19731362
顯示更多
收起更多
-
亞細胞定位:Membrane; Single-pass type I membrane protein.
-
蛋白家族:Type II cytokine receptor family
-
組織特異性:Expressed in colon, liver, lung, pancreas and kidney. No expression in immune cells such as monocytes, T-cells, and NK-cells. Expressed in keratinocytes of normal skin as well as in psoriatic skin lesion. Detected in normal blood brain barrier endothelial
-
數據庫鏈接:
Most popular with customers
-
-
YWHAB Recombinant Monoclonal Antibody
Applications: ELISA, WB, IHC, IF, FC
Species Reactivity: Human, Mouse, Rat
-
Phospho-YAP1 (S127) Recombinant Monoclonal Antibody
Applications: ELISA, WB, IHC
Species Reactivity: Human
-
-
-
-
-